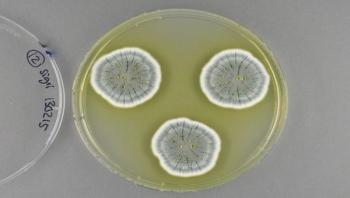

News






A study from Indiana University has found evidence that extremely small changes in how atoms move in bacterial proteins can play a big role in how these microorganisms function and evolve. The research, recently published in the Proceedings of the National Academy of Sciences, is a major departure from prevailing views about the evolution of new functions in organisms, which regarded a protein's shape, or "structure," as the most important factor in controlling its activity.







Hundreds of thousands of babies worldwide die every year from infections that ravage their digestive systems – including those caused by Salmonella and E. coli bacteria. Millions more get sick. Could the difference in survival come not from their immature immune systems, but rather from the mix of bacteria that grow in their tiny guts? New research in mice offers evidence that some of those bacteria – called Clostridia -- provide key protection against infection, in addition to helping digest food. But it also shows that the youngest newborn mice don’t have Clostridia yet, making them the most vulnerable to invading bacteria similar to the pathogens that sicken so many human babies.

One of the most widely used antimicrobial products in use since 1964, triclosan, is also one of the top 10 environmental contaminants in rivers - possibly disrupting the endocrine systems of wildlife and causing toxic effects to their reproduction and development. Now, a new study at the University of Nevada, Reno has found a potential way to reduce the presence of the antimicrobial that is also linked to problems with antibiotic resistance.



Campylobacter and Salmonella caused the most reported bacterial foodborne illnesses in 2016, according to preliminary data published today in CDC’s Morbidity and Mortality Weekly Report. CDC’s Foodborne Diseases Active Surveillance Network (FoodNet) report provides the most up-to-date information about foodborne illnesses in the United States.

Fungi are a potential goldmine for the production of pharmaceuticals. This is shown by researchers at Chalmers University of Technology, who have developed a method for finding new antibiotics from nature's own resources. The findings, which could prove very useful in the battle against antibiotic resistance, were recently published in the journal Nature Microbiology.




Researchers at Johns Hopkins and George Washington universities report new evidence that proteins created by defective forms of HIV long previously believed to be harmless actually interact with our immune systems and are actively monitored by a specific type of immune cell, called cytotoxic T cells.



Viruses that specifically kill bacteria, called bacteriophages, might one day help solve the growing problem of bacterial infections that are resistant to antibiotic treatment. Researchers at Baylor College of Medicine and the Michael E. DeBakey Veterans Affairs Medical Center have determined that phages can effectively reduce bacterial levels and improve the health of mice that are infected with deadly, antibiotic-resistant bacterial 'superbugs.' The study appears in Scientific Reports.